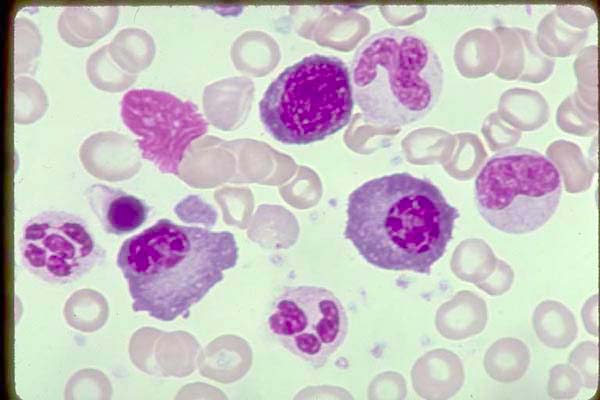
0148-001.jpg

Two Plasma Cells with low nuclear/cytoplasmic ratio, deep basophilic blue cytoplasm, distinct clear area adjacent to the nucleus and eccentrically located nucleus. At the center top edge is a Proerythroblast with a high nuclear/cytoplasmic ratio but deep basophlic blue cytoplasm and dense nuclear chromatin similar to the plasma cells. Its clear area (Golgi) adjacent to the nucleus is not as pronounced as in the plasma cells. 1 late NRBC is at left center as well as a 5-lobed mature neutrophil. Normal marrow - 100X
Image ID: 0148-001
![]() Copyright 1995-2010 - Carden Jennings Publishing Co., Ltd. All rights reserved. The material available at this site is for educational purposes only and is NOT intended for any diagnostic, clinically related, or other purpose. Carden Jennings Publishing Co., Ltd., assumes no responsibility for any use or misuse of this material and makes no warranty or representation of any kind with respect to the material available at this site.
Copyright 1995-2010 - Carden Jennings Publishing Co., Ltd. All rights reserved. The material available at this site is for educational purposes only and is NOT intended for any diagnostic, clinically related, or other purpose. Carden Jennings Publishing Co., Ltd., assumes no responsibility for any use or misuse of this material and makes no warranty or representation of any kind with respect to the material available at this site.